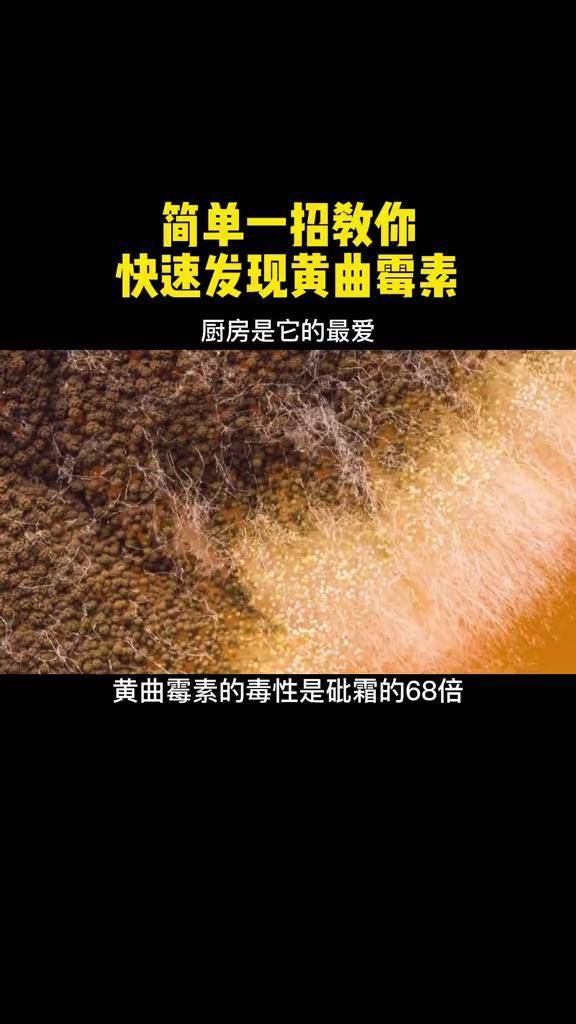
黄曲霉菌

黄曲霉菌的图片

赏一组生长2天的黄曲霉(来源于痰液标本)#显微镜下的世界 #
图片尺寸2156x4096
花生黄曲霉素
图片尺寸720x960
清理,打扫房间,偶然看到一窝"大名鼎鼎"的黄曲霉毒素
图片尺寸1280x1706
黄曲霉菌大侦探!这样判断准没错!
图片尺寸1200x1600
霉变玉米引发肺部感染,深入了解黄曲霉菌风险
图片尺寸1200x800
产生的黄曲霉毒素会致癌?真正的答案来了
图片尺寸1140x756 图片尺寸640x370
图片尺寸640x370
如何识别和防范黄曲霉菌的感染?
图片尺寸1000x633
🧬黄曲霉的形态与危害揭秘🌿
图片尺寸500x666
黄曲霉毒素的威胁与生活中的防范
图片尺寸515x500
馒头放冰箱超过3天会产生黄曲霉毒素,吃了能致癌?真相是
图片尺寸960x640
竟是黄曲霉菌!网友:有毒还致癌,赶紧扔掉!
图片尺寸1920x1080
曲霉菌属与黄曲霉毒素:从污染危害到预防措施解析
图片尺寸520x459
黄曲霉在显微镜下,细节难以察觉,一张图让你轻松看清!
图片尺寸660x881
是黄曲霉菌和寄生曲霉菌等产毒菌株产生的次生代谢产物,是一种强毒性
图片尺寸1660x1520
其中最致命的是黄色的霉菌菌落
图片尺寸1084x570
和众多霉菌相似,黄曲霉呈现出一种毛茸茸的丝状形态
图片尺寸1080x691
大家身边的超级"致癌物":黄曲霉菌,以下玉米身上的黄曲霉菌,网友们有
图片尺寸1770x1280
黄曲霉素实验室培育太麻烦?教你简单方法搞定
图片尺寸720x960
黄曲霉菌
图片尺寸576x1024





图片尺寸640x370